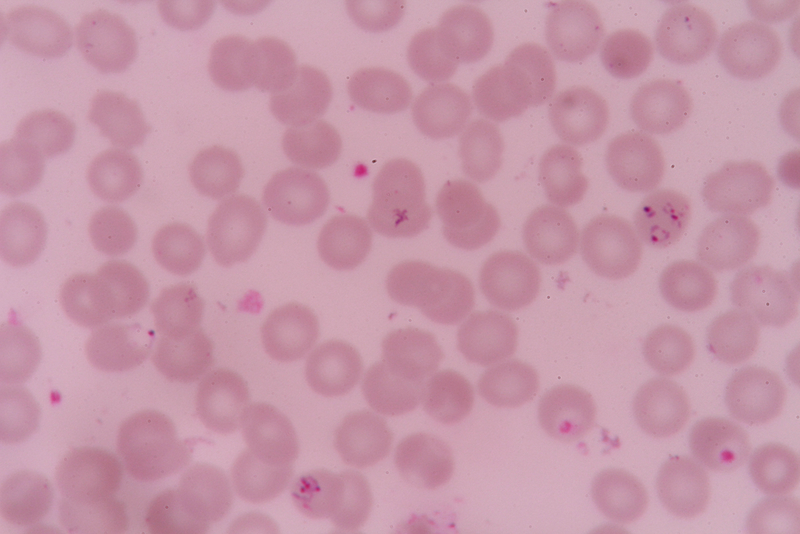

Scientists identify patients resistant to last-line malaria drug
The Telegraph Nov 22, 2018
For the first time in India, medical scientists have identified malaria patients resistant to Artemisinin, a last-line drug used for treatment.
Two studies have found around 20 patients carrying the malaria parasite, displaying partial resistance to Artemisinin. The drug is a combination therapy used to treat patients with Plasmodium falciparum that can cause cerebral malaria. The studies conducted over a 3-year period found that 5 among one group comprising 136 patients and 15 among another group comprising of 226 patients showed no response to the triple combination therapy- artesunate, sulfadoxine, and pyrimethamine.
The parasite continued to stay in the bloodstream after 3 days of treatment displaying signs of early treatment failure and Artemisinin resistance. Scientists have now urged health authorities to look into this issue and revise treatment guidelines.
Information for the article was sourced from The Telegraph. Read the original here.
-
Exclusive Write-ups & Webinars by KOLs
-
Daily Quiz by specialty
-
Paid Market Research Surveys
-
Case discussions, News & Journals' summaries